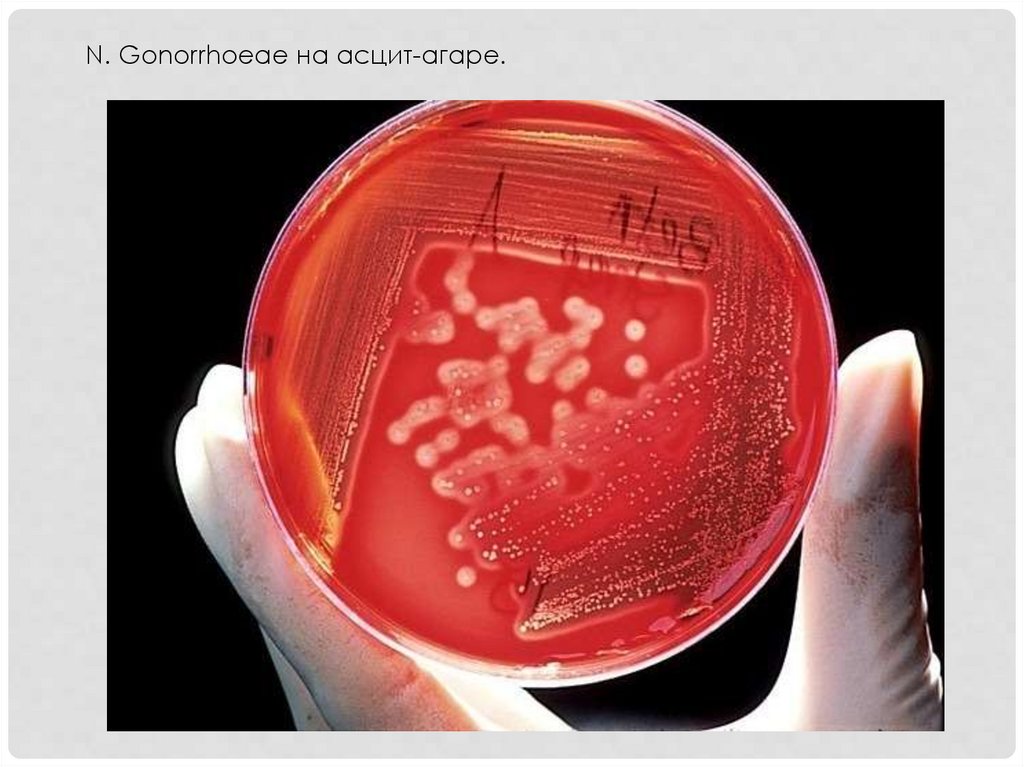

Similar presentations:
Пиогенные кокки
1.
ПИОГЕННЫЕ КОККИ2.
Семейс Видытво, род
Морфотинктори
альные
свойства
Тип Культуральные
дых свойства
ани
я
Факторы
вирулентности
Семей
ство
Staphylo
coccac
eae
Род
Staphylo
coccus
S.
Aureus
S.
Epider
midis
S.
Saprop
hyticus
Гр+ кокки,
неподвиж
.,
Располаг
аются
гроздьям
и, спор
не
образуют
Фак
ульт
ати
вны
е
ана
эро
бы
Не требовательны к
питательным
средам.
ЖСА, на плотных
средах – мутные
круглые колонии
кремового или
желтого цвета
Экзотоксины
(гемолизин,
лейкоцидин и др)
Ферменты
агрессии –
плазмокоагулаза,
ДНКаза,
гиалуронидаза
Поверхностные
белки – белок А,
тейхоевые к-ты
Семей
ство
Streptoc
occace
ae
Род
Streptoc
occus
S.
Pyogen
es
S.
Agalac
tie
S.
Pneum
oniae
Гр+ кокки,
располаг
аются
цепочкой,
неподвиж
ны, спор
не
образуют
Фак
ульт
ати
вны
е
ана
эро
бы
Требовательны,
растут на средах с
добав. Глюкозы или
крови. На плотных –
точечные
бесцветные
колонии, на жидких
– придоннопристеночный рост
Экзотоксины
(стрептолизин О
и S)
Эритрогенин, fc
белок
Ф-ты агрессии
Поверх. Белки +
тейх. К-ты
Капсула
3.
Семейство, род
Виды
Семейст N.
во
menin
Neisseriac gitidis
eae
Род
Neisseria
N.
gonorr
hoeae
Морф.тинкториа
льные
свойства
Тип
дыхани
я
Культуральные
свойства
Факторы
вирулентности
ГрСтрогие Рост только на
диплококки аэробы сывороточных
, спор и
средах.
жгутиков не
Сывороточный
образуют
агар – нежные
полупрозрачные
колонии.
Сывороточный
бульон помутнение,
осадок(t=37гр)
Адгезины
(пили)
Эндотоксин
Капсула
Ф-ты агрессии
–
нейраминидаз
а
Поверхностны
е белки
Рост на средах,
содержащих
человеческий
белок (асцитагар). Колонии
мелкие
блестящие
Адгезин ( пили
и капсульное
в-во)
Por- протеин
Opa-протеин и
протеин 3
Поверх белки
4.
Семейство NeisseriaceaeРод Neisseria
N. Meningitidis - Гр- диплококки, спор и жгутиков не образуют
диплококки, напоминающие кофейные зерна или бобы,
прилегающие друг к другу уплощенными сторонами. Для них
характерно наличие капсулы, а также пилей и ворсинок,
облегчающих адгезию патогенных нейссерий к эпителию.
Для культивирования патогенные нейссерии требуют среды с
кровью, сывороткой крови или асцитической жидкостью
человека. Каждый вид избирательно ферментирует углеводы.
Оптимальная температура +37о С, рН- 7,2-7,4. Для
культивирования пригодны кровяной и шоколадный агар с
добавлением крахмала, нужна повышенная концентрация CO2,
селективные компоненты, подавляющие рост сопутствующей
микрофлоры
5.
6.
7.
Neisseria GonorrhoeaeГр- диплококки, спор и жгутиков не образуют.
Требовательны к питательным средам. Растут на
свежеприготовленных, влажных питательных средах с
добавлением нативного белка (кровь, сыворотка, асцитическая
жидкость). Оптимум рН 7,2-7,4; температуры - 370С.
На плотных питательных средах через 24 часа инкубирования
гонококки, содержащие в клеточной стенке белок II, образуют
прозрачные колонии в виде капелек росы (диаметром 1-3 мм) с
ровным краем.
На жидких питательных средах растут диффузно и образуют
поверхностную пленку, через несколько дней оседающую на дно.
8.
N. Gonorrhoeae на асцит-агаре.9.
10.
ДИФФЕРЕНЦИАЦИЯ ПАТОГЕННЫХНЕЙСЕРИЙ ОТ УСЛОВНОПАТОГЕННЫХ
1. Патогенные растут только при температуре
37гр
2. Колонии патогенных беспигментные,
полупрозрачные
3. Разлагают только глюкозу до кислоты
(гонококки); глюкозу и мальтозу до кислоты
(менингококки)
4. Не образуют сероводород
11.
МЕНИНГОКОККОВАЯ ИНФЕКЦИЯИсточник – бактерионоситель и больной.
Путь передачи – воздушно-капельный.
Клинические формы:
1.Эпидемический менингококковый
цереброспинальный менингит.
2. Менингококцемия (сепсис).
3. Менингококковый назофарингит.
12.
Эпидемический менингококковый цереброспинальный менингит:Материал – спинномозговая жидкость (транспортировка в условиях
термостата).
Первичная микроскопия обязательна.
Первичный посев – сывороточный агар при 37гр.
Накопление культуры на скошенном сывороточном агаре с
последующей идентификацией
Определение серогруппы (р-я агглютинации) по эпид показаниям.
Параллельно с бак исследованием – имуноиндикация.
Менингококцемия:
Материл – кровь.
Посев – сывороточный бульон.
Дополнительный метод – серологический (РПГА с менингококковым
эритроцитарным диагностикумом).
Менингококковый назофарингит:
! Опасность – формирование носительства.
Материал – слизь с задней стенки носоглотки.
Посев на:
• Сывороточный агар с Ристомицином (т = 37гр)
• Сывороточный агар (т = 22гр)
• МПА при температуре 37гр
13.
Гонорея.Источник инфекции – больной.
Пути передачи: половой, контактно-бытовой, инфицирование в
родах.
Клинические формы:
Острая (микроскопия, бак исследовние)
Хроническая (имуноиндикация, серодиагностика,
аллергический метод – внутрикожная проба с убитой
гоновакциной)
Общий метод – ПЦР.
По локализации:
• Урогенитальная форма – восходящая инфекция
• Экстраурогенитальная бленорея (гонорея новорожденных гнойный конъюнктивит, артриты, встречаются ректальные
поражения).
Лечение – АБ терапия, фторхинолоны

medicine
medicine biology
biology








